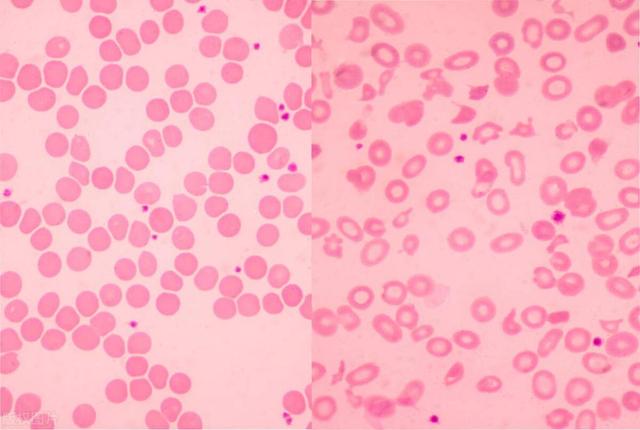

这两天,小孙一直处于激动中,原来他是斑秃患者,以前先后用过三种治疗斑秃的药物,症状有所减轻,但是效果并不理想,症状时轻时重,容易反复,他一直渴望有新药好药问世,能够克服他斑秃的毛病。
原来,他从网上看到,有一种新药叫艾玛昔替尼已经做完临床试验,2024年9月5日已经向国家药品监督管理局药品审评中心提出申请,而且已经受理,即将获得批准,不久的将来,他就可以使用这种新药了,所以非常激动。

斑秃患者
那么这款新药究竟是什么呢?
艾玛昔替尼片,是恒瑞医药子公司瑞石生物研制的1类新药、新一代JAK1抑制剂。 2022年11月15日,恒瑞医药宣布,艾玛昔替尼片用于治疗成人和12岁及以上青少年特应性皮炎的III 期国际多中心临床研究 QUARTZ3,经评估达到研究预设的共同主要终点及所有关键次要终点,已经向国家药品监督管理局药品审评中心提出上市申请,不久的将来就可能上市使用。
艾玛昔替尼一药有多种用途
艾玛昔替尼不是单一用途的药物,它可以治疗多种疾病,是一药多用的新药,此前已经在中国递交3项上市申请,分别为强直性脊柱炎、特应性皮炎、类风湿关节炎,加上的斑秃未第四适应症,可以说达到了一药多用的目的。

强制性脊柱炎

类风湿关节炎
艾玛昔替尼是新一代高选择性JAK1抑制剂
JAK抑制剂可选择性抑制 JAK 激酶,阻断 JAK/STAT 通路,JAK-STAT信号通路是近年来发现的一条由细胞因子刺激的信号转导通路,参与细胞的增殖、分化、凋亡以及免疫调节等许多重要的生物学过程。
临床上JAK抑制剂主要用于筛选血液系统疾病、肿瘤、类风湿性关节炎及银屑病等治疗药物。但是JAK有4个家族成员,分别是JAK1、JAK2、TYK2和JAK3/,前3者广泛存在于各种组织和细胞中,而JAK3仅存在于骨髓和淋巴系统,所以研发药物时,选择性越高,活性越强,治疗效果越好。艾玛昔替尼是我国自主研发的新一代高选择性JAK1抑制剂,对JAK1的选择性是对JAK2的16倍。该药物能通过高选择性抑制JAK1,调节IL-4、IL-5、IL-13、IFN-γ和其他参与AD发病机制的细胞因子的信号传导。
艾玛昔替尼是新一代高选择性JAK1抑制剂,选择性更强、更高,作用更好,是理想的治疗药物。
艾玛昔替尼降低发生中性粒细胞减少症与贫血的风险
中性粒细胞减少症是由于周围血中粒细胞的绝对值减少而出现的一组综合征。轻症患者不出现特殊症状,中重度患者出现疲劳、发力等非特异症状,感染的风险不同程度的增加,当中性粒细胞绝对值低于0.5×109/l时,称为粒细胞减少症,病死率比较高,而贫血会出现乏力,且会引发多器官和系统的不同症状,包括头痛、耳鸣、晕厥、肌肉无力、气短、心悸、消化不适、月经不调、性功能减退等,也对健康产生危害。
贫血
艾玛昔替尼对JAK1抑制性比较强,而对JAK2的抑制性极低,所以能尽量降低发生中性粒细胞减少症与贫血的风险。
临床试验结果显示,艾玛昔替尼治疗斑秃疗效确切
在新药上市前需要进行规范的临床试验,只有完成一期、二期、三期临床试验,才可以申请上市,从二期数据显示:2mg、4mg、8mg艾玛昔替尼及安慰剂治疗斑秃,24周SALT较基线下降30.51%、56.11%、51.01%和19.8%。可以发现艾玛昔替尼在2mg/日、4mg/日呈现剂量依赖性,但是在4mg/日、8mg/日这两个剂量上没有剂量依赖,所以艾玛昔替尼在4mg就能达到它的治疗效应。
艾玛昔替尼的三期临床试验也已经完成,达到了共同主要终点及所有关键次要终点,满足了上市使用的条件,已经提出上市申请。
艾玛昔替尼的安全性是可靠的
在新药的三期临床试验中,主要是疗效与安全性试验,只有疗效与安全性都过关的,才是可靠的,才可以有条件进行新药申请,才可以获得审评,从目前多中心的临床试验结果看,达到了预期的目的,疗效确切,安全性是可靠的。
真棒!新药艾玛昔替尼一药多用,治疗直性脊柱炎、特应性皮炎、类风湿关节炎多种疾病,加上即将获批的斑秃总计四种疾病,是非常有潜力的治疗药物,值得临床选择使用。